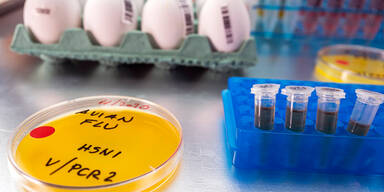
Vogelgrippe

In den USA ist erstmals ein Mensch nach einer Infektion mit dem Vogelgrippevirus H5N1 gestorben.
Es handle sich um eine Person, die älter als 65 Jahre gewesen sei und auch andere gesundheitliche Probleme gehabt habe, teilte die Gesundheitsbehörde des Bundesstaates Louisiana am Montag mit. Der Patient habe sowohl mit Wildvögeln als auch mit einem Schwarm in seinem Garten Kontakt gehabt, teilte die Behörde mit, ohne nähere Details zu nennen.
Bereits im Dezember hatte die Behörde gemeldet, dass es sich bei dem Menschen um den ersten Patienten in den USA gehandelt habe, der nach einer Infektion mit dem Vogelgrippe-Virus H5N1 schwer erkrankt sei.
Risiko für Allgemeinbevölkerung weiter gering
Die Vogelgrippe H5N1 ist derzeit bei Wildvögeln auf der ganzen Welt weit verbreitet, auch zahlreiche wildlebende Säugetiere infizieren sich. Außerdem führte das Virus jüngst zu Ausbrüchen in Geflügelbetrieben sowie in Milchbetrieben in den USA.
Wie groß das Ausmaß ist, ist wegen fehlender Daten aber weitgehend unklar. Die CDC verzeichnete Fälle vor allem unter Mitarbeitern von Milchvieh- und Geflügelbetrieben, mit milden Verläufen. Mensch-zu-Mensch-Übertragen wurden bisher nicht nachgewiesen. Die CDC schätzt das Risiko für die Allgemeinbevölkerung weiterhin als gering ein. Berichtet wurde zuletzt von etwa 60 Fällen bei Menschen, darunter zuletzt auch erstmals ein Kind.